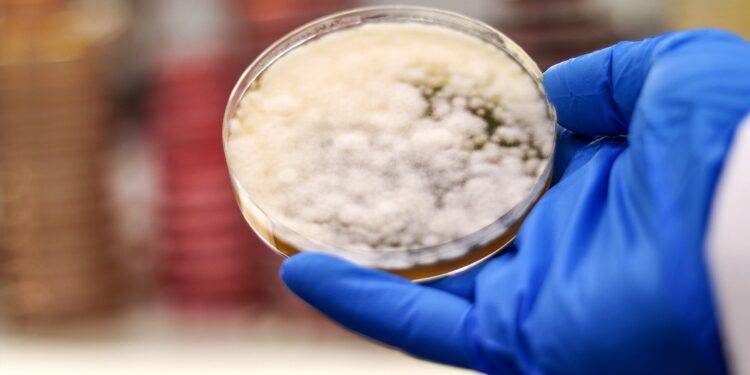
Crean carne para hamburguesas con hongos modificados genéticamente

(14 de marzo del 2024. El Venezolano).- Un equipo de científicos ha creado un sustituto de la carne a partir de los hongos con la ayuda de la ingeniería genética, según un estudio publicado este jueves en la revista Nature.
Investigadores de la Universidad de Berkeley, el Instituto Conjunto de BioEnergía (EE.UU.) y del Centro de Biosostenibilidad de la Fundación de Novo Nordisk (Dinamarca) tomaron el hongo ‘Aspergillus oryzae’, conocido como koji, para llevar a cabo modificaciones en su genoma y transformarlo a una fuente de alimento.
Concretamente, aumentaron la producción de hemo del hongo, una molécula a base de hierro presente en muchos organismos, que da a la carne su color y sabor característicos, y de ergotioneína, un antioxidante asociado con beneficios para la salud cardiovascular.
Tras introducir estos cambios, los hongos, que antes eran blancos, se volvieron rojos, y al eliminar el exceso de agua y triturarlos, se les pudo dar forma de hamburguesa.
Ahora, los científicos buscan que los hongos se vean más apetecibles mediante modificaciones de los genes que controlan su textura. «Creemos que hay mucho margen para explorar la textura modificando la morfología fibrosa de las células. Así, podríamos configurar la estructura de las fibras de los hongos para que sean más largas, lo que daría una experiencia más parecida a la carne», señaló el bioingeniero Vayu Maini Rekdal, coautor del estudio.